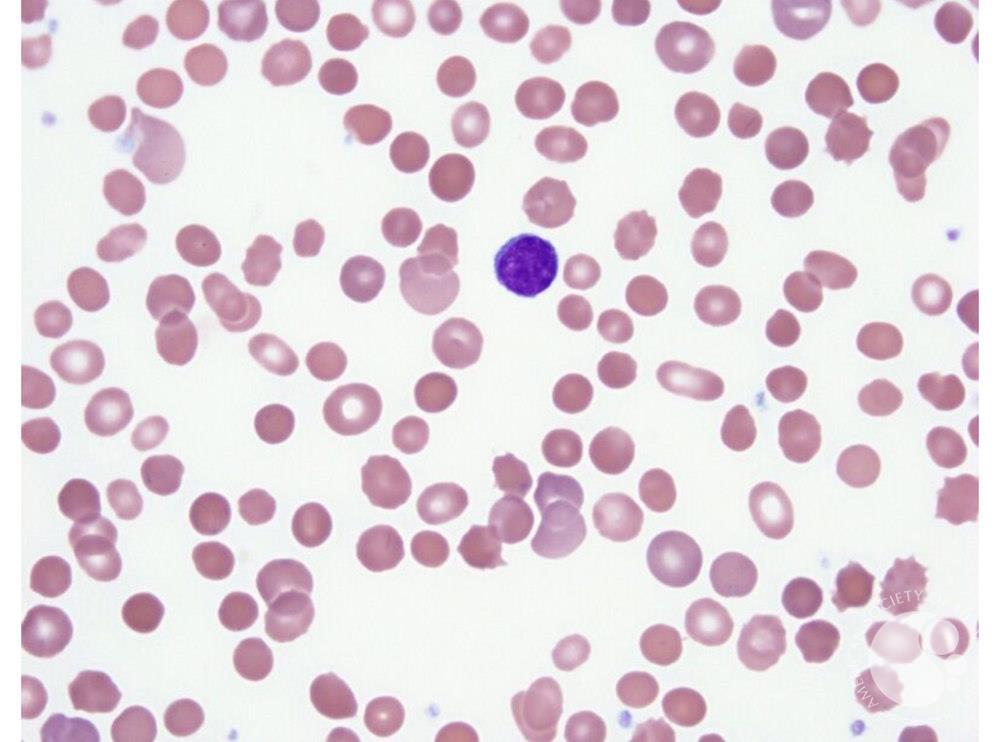
Spherocytes hereditary spherocytosis Spherocytes hereditary spherocytosis

Tren Gaya 25+ Hereditary Spherocytosis
Poin pembahasan Tren Gaya 25+ Hereditary Spherocytosis adalah :
Tren Gaya 25+ Hereditary Spherocytosis. Mempunyai obat sehat mungkin adalah salah satu impian terbesar untuk setiap keluarga. Waktu untuk menghilangkan penat selesai bekerja dan bersantai bersama keluarga. Jika dulu tempat tinggal dijadikan untuk tempat perlindungan dari perubahan cuaca serta untuk melindungi diri dari terjangan hewan buas kegunaan hunian pada era modern ini untuk tempat istirahat setelah selesai menjalankan berbagai aktifitas di luar dan juga digunakan sebagai wadah buat mempererat keharmonisan antar keluarga. Sebab itu setiap orang tentunya memiliki tempat tinggal idaman yang berbeda beda. Simak ulasan terkait obat sehat dengan artikel Tren Gaya 25+ Hereditary Spherocytosis berikut ini

Hereditary spherocytosis Wikipedia Sumber en.wikipedia.org

2020 Exam I Medical Laboratory Science 460 with Butina Sumber www.studyblue.com

Hematopathology Images at University Of Alabama School Of Sumber www.studyblue.com

NEJM Resident 360 on Twitter Hereditary spherocytosis Sumber twitter.com

Pathology Thread Sumber www.med-ed.virginia.edu

How Hereditary Spherocytosis Causes Anemia YouTube Sumber www.youtube.com

Pathology Red Blood Cell Disorders at Community Technical Sumber www.studyblue.com
Spherocytes hereditary spherocytosis Sumber imagebank.hematology.org

Hereditary Spherocytosis YouTube Sumber www.youtube.com

Hereditary spherocytosis Autoimmune diseases articles Sumber www.steadyhealth.com

Anemia Pathology 1 with Schneider at Rosalind Franklin Sumber www.studyblue.com

HS Sumber nonada0.tripod.com

Anemia at University of California Davis StudyBlue Sumber www.studyblue.com

Hereditary Spherocytosis HS YouTube Sumber www.youtube.com

Pathology Images at University Of Alabama School Of Sumber www.studyblue.com
fatigue., shortness of breath., irritability., dizziness or lightheadedness., increased heart rate., headache., heart palpitations., jaundice.,
Tren Gaya 25+ Hereditary Spherocytosis. Mempunyai obat sehat mungkin adalah salah satu impian terbesar untuk setiap keluarga. Waktu untuk menghilangkan penat selesai bekerja dan bersantai bersama keluarga. Jika dulu tempat tinggal dijadikan untuk tempat perlindungan dari perubahan cuaca serta untuk melindungi diri dari terjangan hewan buas kegunaan hunian pada era modern ini untuk tempat istirahat setelah selesai menjalankan berbagai aktifitas di luar dan juga digunakan sebagai wadah buat mempererat keharmonisan antar keluarga. Sebab itu setiap orang tentunya memiliki tempat tinggal idaman yang berbeda beda. Simak ulasan terkait obat sehat dengan artikel Tren Gaya 25+ Hereditary Spherocytosis berikut ini
Hereditary spherocytosis Wikipedia Sumber en.wikipedia.org
Hereditary spherocytosis Genetics Home Reference NIH
15 10 2020 Hereditary spherocytosis is a condition that affects red blood cells People with this condition typically experience a shortage of red blood cells anemia yellowing of the eyes and skin jaundice and an enlarged spleen splenomegaly Most newborns with hereditary spherocytosis have severe anemia although it improves after the first year of life

2020 Exam I Medical Laboratory Science 460 with Butina Sumber www.studyblue.com
Hereditary Spherocytosis Causes Diagnosis and Treatments
Hereditary spherocytosis HS is a disorder of the surface called the membrane of your red blood cells It causes your red blood cells to be shaped like spheres instead of flattened discs that

Hematopathology Images at University Of Alabama School Of Sumber www.studyblue.com
Hereditary Spherocytosis HS information and treatment
Hereditary spherocytosis is the predominant cause of spherocytosis and is caused by several genetic mutations that lead to membrane abnormalities of red blood cells The disease usually is inherited as an autosomal dominant trait although a few people with hereditary spherocytosis may develop it secondary to new mutations

NEJM Resident 360 on Twitter Hereditary spherocytosis Sumber twitter.com
Hereditary Spherocytosis Treatment Symptoms Diagnosis
01 01 2020 Spherocytosis in most cases is an inherited disease that changes the shape of and decreases the life of red blood cells This destruction of the red blood cells leads to anemia The shape of a normal red blood cell looks like a disk Normal red blood
Pathology Thread Sumber www.med-ed.virginia.edu
Hereditary Spherocytosis Practice Essentials
19 06 2020 Hereditary spherocytosis is a condition characterized by hemolytic anemia when red blood cells are destroyed earlier than normal Signs and symptoms can range from mild to severe and may include pale skin fatigue anemia jaundice gallstones and or enlargement of the spleen Other symptoms of hemolytic anemia may include feeling that your heart is pounding or racing palpitations

How Hereditary Spherocytosis Causes Anemia YouTube Sumber www.youtube.com
Hereditary Spherocytosis
09 03 2020 Hereditary spherocytosis HS is an inherited condition that affects your red blood cells The red blood cells are those that carry oxygen around the body Their shape like a slightly elongated saucer helps them carry oxygen effectively In HS there is a defect in the outer layer of the red blood

Pathology Red Blood Cell Disorders at Community Technical Sumber www.studyblue.com
Spherocytosis Wikipedia
Spherocytes hereditary spherocytosis Sumber imagebank.hematology.org
Hereditary spherocytosis Genetic and Rare Diseases

Hereditary Spherocytosis YouTube Sumber www.youtube.com
Hereditary Spherocytosis How is HS inherited Patient
Hereditary spherocytosis Autoimmune diseases articles Sumber www.steadyhealth.com

Anemia Pathology 1 with Schneider at Rosalind Franklin Sumber www.studyblue.com
HS Sumber nonada0.tripod.com

Anemia at University of California Davis StudyBlue Sumber www.studyblue.com

Hereditary Spherocytosis HS YouTube Sumber www.youtube.com

Pathology Images at University Of Alabama School Of Sumber www.studyblue.com
0 Comments